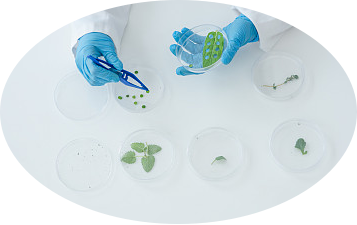
image.png

多酚氧化酶(PPO)|生化指标
2025-03-24
多酚氧化酶(Polyphenol oxidase, PPO)是一类含铜的氧化还原酶,属于六大酶类中的氧化还原酶(EC 1.10.3.1),
广泛分布于植物、真菌和昆虫中。多酚氧化酶是一种含铜的金属蛋白酶,
其活性中心通常含有两个铜离子,这两个铜离子在酶的催化过程中起着关键作用。不同来源的多酚氧化酶在结构上可能存在一定差异,但都具有相似的催化结构域。
生理功能
防御反应:当植物受到机械损伤、病虫害侵袭或逆境胁迫时,PPO 被激活。它催化酚类物质氧化生成醌类,醌类物质对微生物具有毒性,可抑制其生长繁殖,同时醌类进一步聚合形成黑色素等深色物质,使受伤部位颜色变深,从而阻止病虫害的进一步侵害,起到保护植物的作用。
参与光合作用:PPO 参与植物叶绿体中质体醌的合成,质体醌在光合作用的电子传递过程中起着重要作用,影响光合作用的效率。
调节激素平衡:PPO 可通过氧化酚类物质影响植物激素如生长素、细胞分裂素等的代谢和分布,进而调节植物的生长发育过程,如影响植物的生根、发芽、开花和结果等。
花色形成:在一些植物中,PPO 参与花色形成过程。它催化花色苷等色素前体物质的氧化聚合,使花朵呈现出不同的颜色,吸引传粉者,有利于植物的繁殖。